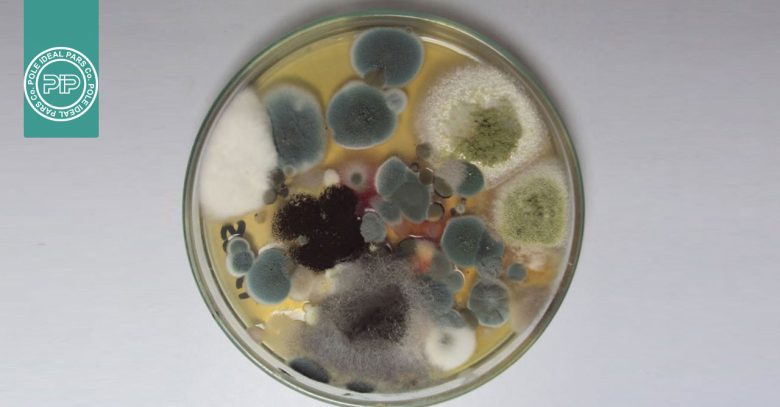
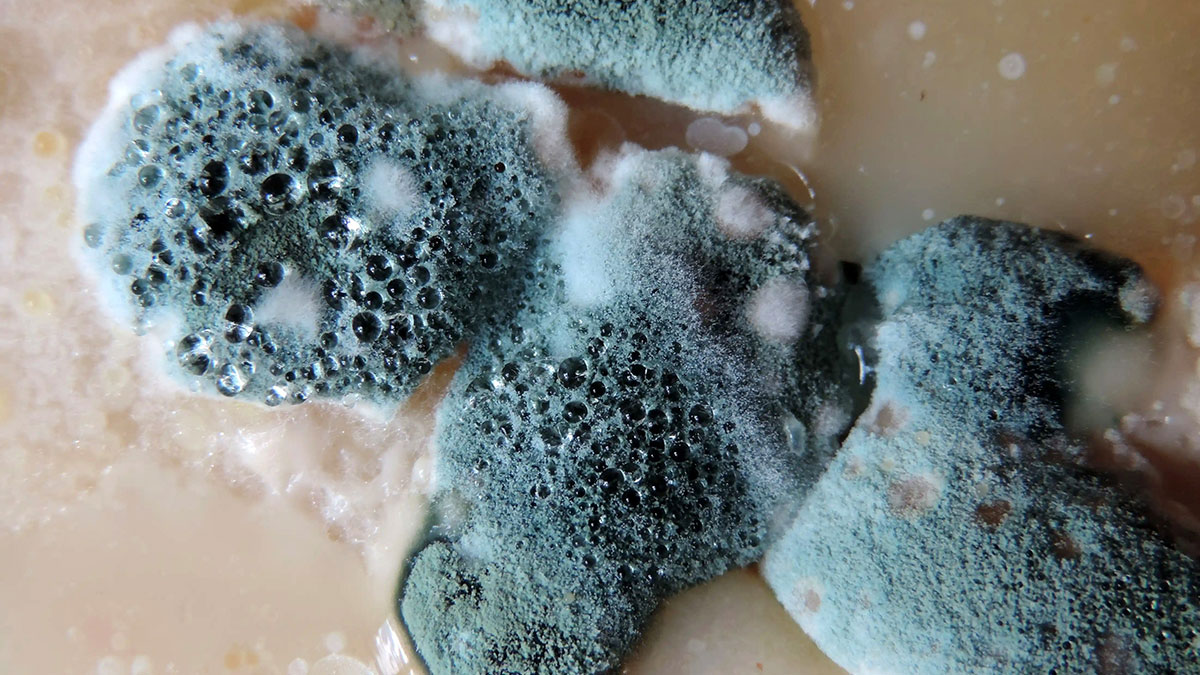
تعریف و شناخت کپک‌ها
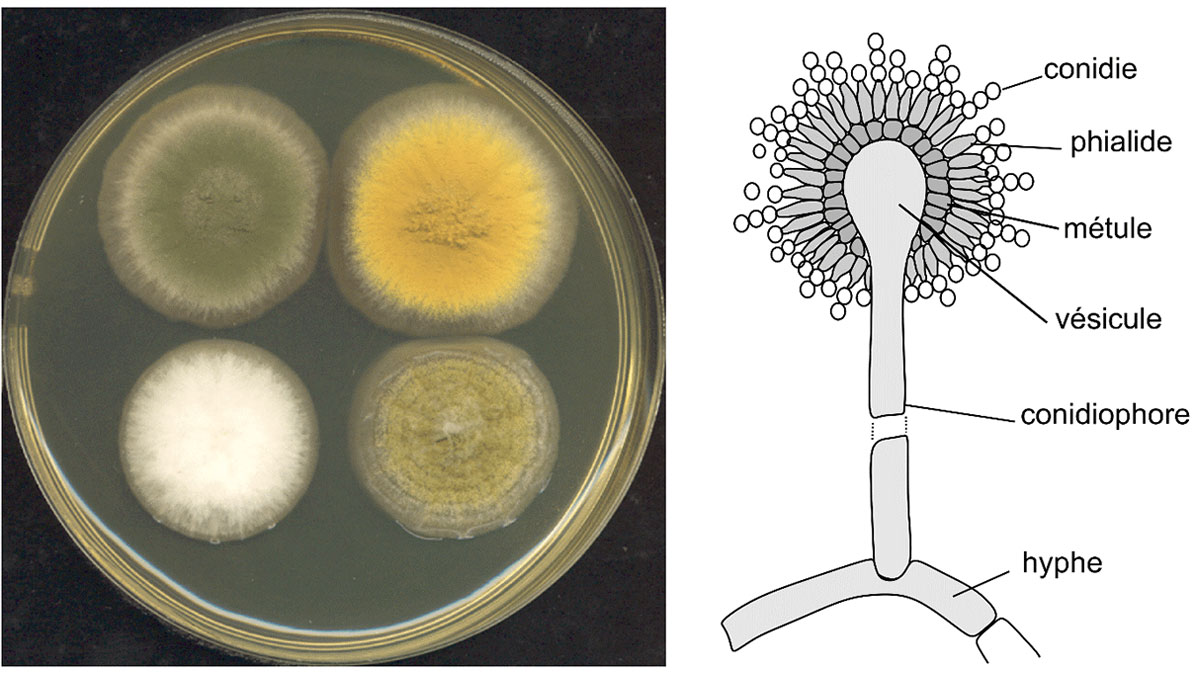
خصوصیات کپک‌ها از نظر مورفولوژیکی

خصوصیات کپکها: شناخت ساختار، رشد و رفتار این قارچهای میکروسکوپی
کپکها (Molds) نوعی قارچ میکروسکوپی و مولتیسلولی هستند که در محیطهای طبیعی، غذایی و آزمایشگاهی رشد میکنند. شناخت خصوصیات کپکها برای میکروبیولوژیستها، زیستشناسان، صنایع غذایی و دارویی اهمیت زیادی دارد. زیرا میتواند به کنترل فساد، تشخیص گونهها و استفاده علمی از کپکها کمک کند.
در این مقاله، با ساختار، ویژگیهای مورفولوژیکی، محیط کشتی و فیزیولوژیکی، شرایط رشد، تکثیر و کاربردهای کپکها آشنا میشویم و نکات مهمی که در تشخیص و کنترل کپکها کاربرد دارند بررسی خواهیم کرد. پس در ادامه با ما همراه باشید.
تعریف و شناخت کپکها
کپکها نوعی میکروارگانیسم هستند که معمولاً روی مواد غذایی مانند نان، میوهها، سبزیجات و ژلهها رشد میکنند. یکی از ویژگیهای مهم کپکها این است که میتوانند مواد غذایی را فاسد کنند و غیرقابل مصرف نمایند. با این حال، برخی گونهها در تولید پنیر، خوراکیهای سنتی و صنایع دارویی مفید هستند.
کپکها از نظر ساختاری به صورت رشتههای بلند و شبکهای به نام هیفا (Hyphae) رشد میکنند و تجمع این هیفاها یک توده گسترده به نام میسلیوم (Mycelium) را تشکیل میدهد. این ساختار باعث ظاهر پنبهای، پفکرده یا مخملی کپک روی سطح مواد غذایی یا محیطهای کشت میشود.
خصوصیات کپکها از نظر مورفولوژیکی
- هیفاها: میتوانند سپتات (دارای دیواره عرضی) یا غیرسپتات (بدون دیواره عرضی) باشند.
- تفاوت هیفاها: هیفاها ممکن است تغذیهای (Vegetative) یا تولیدی (Fertile) باشند که نقش متفاوتی در رشد و تکثیر دارند.
- تکثیر: عمدتاً از طریق اسپورهای غیرجنسی انجام میشود، اما برخی گونهها میتوانند اسپورهای جنسی نیز تولید کنند.
- ظاهر کلنی: کپکها میتوانند مخملی، خشک و پودری، مرطوب یا ژلاتینی، شل و افتاده یا فشرده و متراکم باشند. ظاهر کپکها در محیط کشت معمولاً به شناسایی جنس آنها کمک میکند.
خصوصیات کپکها در محیط کشت
کپکها بر اساس ظاهر رشد در محیطهای کشت قابل شناسایی هستند:
- کپکهای کامل بدون سپتا (Non-septate Perfect Molds): شامل اوومایکوتها (Oomycetes) و زایگومایکوتها (Zygomycetes)
- کپکهای کامل (Perfect Molds): شامل آسکومایکوتها (Ascomycetes) و باسیدیومایکوتها (Basidiomycetes)
ظاهر سطح کپکها نیز متنوع است:
- برخی مخملی و نرم
- برخی خشک و پودری
- برخی مرطوب یا ژلاتینی
- برخی کپکهای قدیمی شل و افتاده یا متراکم و فشرده هستند.
این ویژگیها در تشخیص جنس و گونه کپکها اهمیت زیادی دارد.
خصوصیات فیزیولوژیکی کپکها
خصوصیات کپکها از نظر فیزیولوژیکی شامل شرایط محیطی مورد نیاز برای رشد است:
- نیاز به دما: بیشتر کپکها در دمای معمولی محیط (۲۰–۳۵ درجه سانتیگراد) رشد میکنند، برخی در دمای پایین یخچال و تعداد محدودی در دمای بالا نیز رشد دارند.
- نیاز به رطوبت: کپکها به رطوبت کمتری نسبت به باکتریها و مخمرها نیاز دارند. اگر مواد غذایی خشک رطوبت کمتر از ۱۴–۱۵٪ داشته باشند، رشد کپکها مهار یا به تأخیر میافتد.
- نیاز به اکسیژن: کپکها معمولاً هوازی هستند و برای رشد به اکسیژن نیاز دارند.
تکثیر و اسپورها
- کپکها عمدتاً از طریق اسپورهای غیرجنسی تکثیر میشوند که بسیار کوچک هستند و میتوانند توسط هوا، آب یا حشرات منتشر شوند.
- گونههای خاص میتوانند اسپورهای جنسی تولید کنند که بسته به نوع و شرایط محیطی متفاوت است.
ظاهر و رنگ کپکها

ظاهر کلنیهای کپکها بسیار متنوع است و میتواند به شناسایی جنس آنها کمک کند. علاوه بر شکل و رنگ، نوع محیط کشت نیز بر ظاهر کپک اثر میگذارد. کپکهای قدیمی ممکن است شل و افتاده شوند یا فشرده و متراکم باقی بمانند. در ادامه چند مثال از خصوصیات کپکهای رایج روی محیط کشت های مختلف را بررسی خواهیم کرد.
Aspergillus niger
- محیط کشت: پلیت سابسترای غذایی یا Potato Dextrose Agar
- ظاهر: کونیهای سیاه و پودری با سطح متراکم
- ویژگیها: رشد سریع و تولید اسپورهای سیاه که باعث پوشش کامل محیط میشود
Penicillium chrysogenum
- محیط کشت PDA یا محیط کشت غذایی مرطوب
- ظاهر: کلنیهای سبز یا آبی روشن با حاشیههای پنبهای
- ویژگیها: سطح نرم و مخملی، که در تولید پنیر و برخی آنتیبیوتیکها کاربرد دارد
Rhizopus stolonifer
- محیط کشت: نان، کیک یا محیط سابسترای نشاستهای
- ظاهر: کلنیهای سفید در ابتدا، سپس سیاه با رشتههای بلند هیفا
- ویژگیها: سطح پنبهای و پراکنده، اغلب با اسپورهای سیاه روی ساقه
Mucor spp.
- محیط کشت: محیط مرطوب PDA یا سبزیجات فاسد
- ظاهر: کلنیهای خاکستری تا سفید، نرم و ژلاتینی
- ویژگیها: بهصورت شل و افتاده رشد میکند، در بعضی مواد غذایی باعث فساد سریع میشود
Cladosporium spp.
- محیط کشت:محیط کشت مرطوب یا سطوح خارجی میوه و سبزیجات
- ظاهر:کلنیهای سبز تا سیاه، پودری و فشرده
- ویژگیها: معمولاً کند رشد است، اما مقاوم و پایدار در محیطهای سرد
این مثالها نشان میدهند که ظاهر و رنگ کپکها به نوع جنس و محیط کشت وابسته است و میتواند به شناسایی سریع کپکها کمک کند. شناخت این نکات برای کنترل کیفیت مواد غذایی و آزمایشگاهها اهمیت زیادی دارد.
نقش و کاربردهای کپکها
کپکها در طبیعت، صنایع غذایی و دارویی کاربردهای متعددی دارند. برخی از کاربردهای مهم در ادامه ذکر شده است.
- طبیعت: تجزیه مواد آلی مرده و مشارکت در چرخه مواد.
- صنایع غذایی: تولید پنیر، تمپه، برخی غذاهای سنتی و فرآوردههای تخمیری.
- صنایع دارویی و بیوتکنولوژی: تولید آنزیمها، آنتیبیوتیکها و محصولات متابولیکی مفید.
- خطرات سلامتی: برخی کپکها میتوانند مایکوتوکسین (ترکیبات سمی) تولید کنند که وارد زنجیره غذایی شده و خطرناک هستند.
سخن پایانی
خصوصیات کپکها شامل مورفولوژی، ظاهر کلنی، نیازهای فیزیولوژیکی و محیط کشتت آنها میشود. شناخت این خصوصیات برای تشخیص گونهها، کنترل رشد کپکها و بهرهبرداری علمی از آنها حیاتی است.
با توجه به ظاهر، رنگ، رطوبت، دما و نوع اسپور، میتوان محیطهای مناسب برای رشد یا مهار کپکها را شناسایی کرد. کپکها هم میتوانند مخرب باشند و هم سودمند، بسته به کاربردشان در صنایع غذایی، دارویی یا تحقیقات علمی.
انتخاب و مدیریت درست کپکها، کلید ایمنی، کیفیت و موفقیت آزمایشها و تولیدات صنعتی است. امیدواریم این مقاله مورد توجه شما قرار گرفته باشد.



